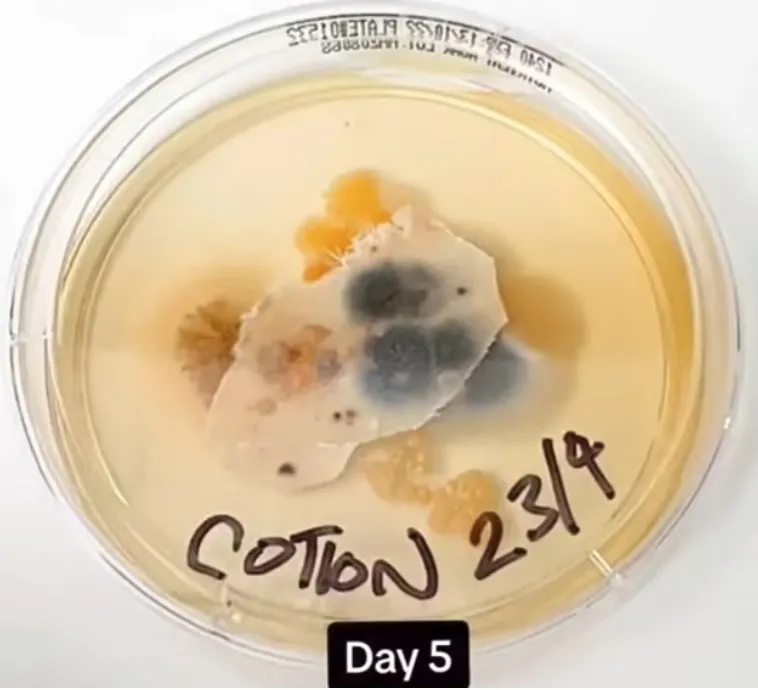
Спустя пять дней инкубации дерматологи собрали богатый урожай из бактерий и грибков, живущих на постельном белье.

Тесты выявили три миллиона бактерий, живущих на грязных наволочках
- 28 июня 2023 13:43
- Вениамин Ветролесов
Дерматологи из американской компании AmeriSleep, производящей матрасы, провели шокирующий эксперимент, который показал, что постельное бельё в течение недели собирает миллионы колоний бактерий. Это больше, чем на сиденье для унитаза, поскольку хлопок и шёлк прекрасно вбирают споры грибков, микробы и вирусы, которые остаются от омертвевших клеток кожи, пота и слюны.
В ходе тестирования учёные собрали образцы нестираных наволочек и оставили их для инкубации на семь дней. Спустя неделю команда выявила бактерии, которые могут вызывать кожные воспаления, и они отлично размножаются в мешанине из косметики, лосьонов, пота, волос, перхоти и прочих продуктов жизнедеятельности.
Мёртвые клетки кожи и пот также служат пищей для пылевых клещей, привлекая их к постели и помогая им размножаться. Одним из наиболее распространённых видов бактерий, которые встретились на постельном белье, был золотистый стафилококк, вызывающий разнообразные инфекции кожи, фурункулы и угри.
Таким образом, выяснилось, что в среднем на обычной наволочке живут три миллиона колоний бактерий, которые размножаются в течение недели. Помимо стафилококков, были обнаружены бациллы, которые могут вызывать глазные инфекции и эндокардит, а грамположительные кокки провоцируют устойчивые инфекции. Дерматологи заключили, что стоит менять наволочки не реже двух раз в неделю, а не раз в месяц, как это принято в обычной семье.
- Телеграм
- Дзен
- Подписывайтесь на наши каналы и первыми узнавайте о главных новостях и важнейших событиях дня.


Войти через социальные сети: